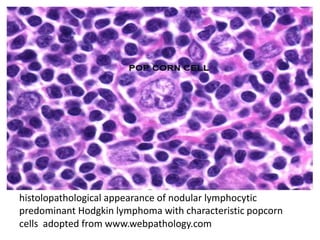
histolopathological appearance of nodular lymphocytic
predominant Hodgkin lymphoma with characteristic popcorn
cells adopted from www.webpathology.com

A 12-year-old female patient was diagnosed with Hodgkin lymphoma, nodular lymphocytic predominant type, after initially presenting with abdominal pain and cervical lymphadenopathy. She underwent treatment consisting of 4 courses of ABVD/COEP and radiation, achieving complete response, and has been in remission for over 2.5 years with ongoing follow-up. The document raises questions regarding treatment decisions and the role of PET-CT in managing her condition.